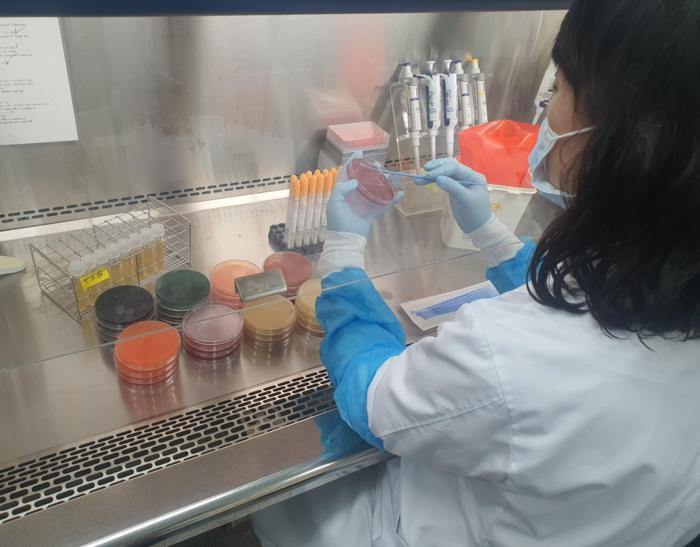

경기북부 지역 어린이집 및 유치원 조리실 환경검체에 대한 안전성 검사 이미지(사진=경기도 제공)
[경기뉴스탑(의정부)=이윤기 기자]경기도보건환경연구원 북부지원이 경기북부 지역 어린이집 및 유치원 조리실 환경검체에 대한 안전성 검사를 실시한 결과, 모든 시설에서 식중독세균과 노로바이러스가 검출되지 않았다고 19일 밝혔다.
연구원은 지난 3월부터 5월까지 2022년 식중독 발생 이력이 있거나 점검이 요구되는 어린이집 및 유치원 10곳(어린이집 7곳과 유치원 3곳)을 대상으로 냉장고, 조리대 등의 환경검체를 채취해 식중독세균과 노로바이러스 검사를 시행했다.
경기도보건환경연구원 북부지원은 이번 검사가 하절기를 앞두고 세균성 감염병 증가에 대한 예방적 차원에서 이뤄졌다고 설명했다. 시설마다 8~10건 정도의 검체를 채취해 검사한 결과, 모든 검체에서 식중독세균 10균속과 노로바이러스가 검출되지 않았다.
권보연 경기도보건환경연구원 북부지원장은 “여름철 기온 상승에 따라 어린이집 등 영유아 시설의 식중독 발생 증가가 예상되는 만큼 선제적 검사를 통한 사전 예방으로 건강한 급식 환경 조성을 위해 노력하겠다”고 말했다.







![[현장기획] 10월, 의정부에서 만나는 자연·문화·역사…가을 나들이 명소 총집합](../data/cheditor4/2509/dd78a3767634f541ccd872c1c10a60daeba7d73b.jpg)
![[현장기획]빛과 예술의 도시 '수원'에서 보내는 특별한 명절.. 미디어아트·야간개장·무료 공연까지](../data/cheditor4/2509/8d2ba902b750b6a45e580e784d48a09c63fd33c7.jpg)
![[기획특집]“이웃과 마음 나누는 특별한 냉장고”…안양시 공유냉장고 이야기](../data/cheditor4/2508/f6e3b323c7d12e933b9d02ec3f2cc7c2fd40a736.jpg)










